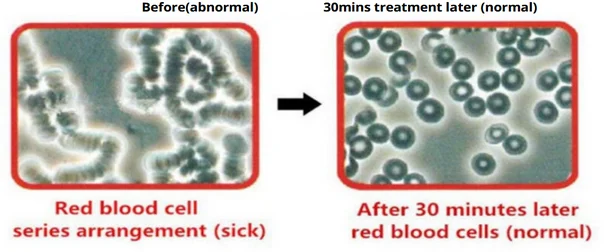

Wuhan Cozing Medical Devices Co.. Ltd(Copy)
Business Type:Manufacturer
Main Products: pain relief laser Hair Loss Productsknee pain massagerObstetrics And Gynecology,Assisted ReprLaser Beauty Equipmentled light therapy machine prostate massager medical laser watch Physical Therapy Equipmentsportable oxygen generator
view on mobile

Rhinitis Red Light Treatment Stuffy Nose Nasal Sinusitis Cold Cure Allergy Reliever Therapy Device
Medical & Health & Beauty Home Medical
MOQ:1 Piece(s)
Payment Method : L/C T/T D/P Western Union Paypal Money Gram
Keywords:rhinitis treatment tinnitus era ringing therapy